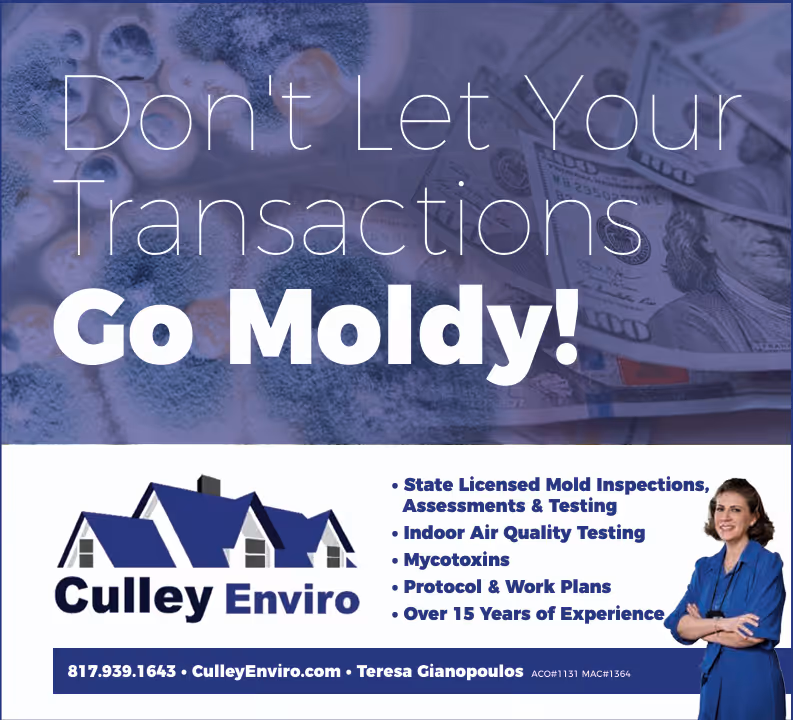

Culley Enviro LLC is a TDLR licensed Mold Assessment Company with experienced Mold Assessment Consultants at your service. We have been in the water damage and mold industry since 2007. We specialize in Mold and Indoor Air Quality, that's all we do. Mold never has to be scary or a deal breaker at a property. We can help individuals and families step thru stressful mold and mycotoxin situations that may ever arise.
We are a proud sponsor of our local Real Producers magazine.